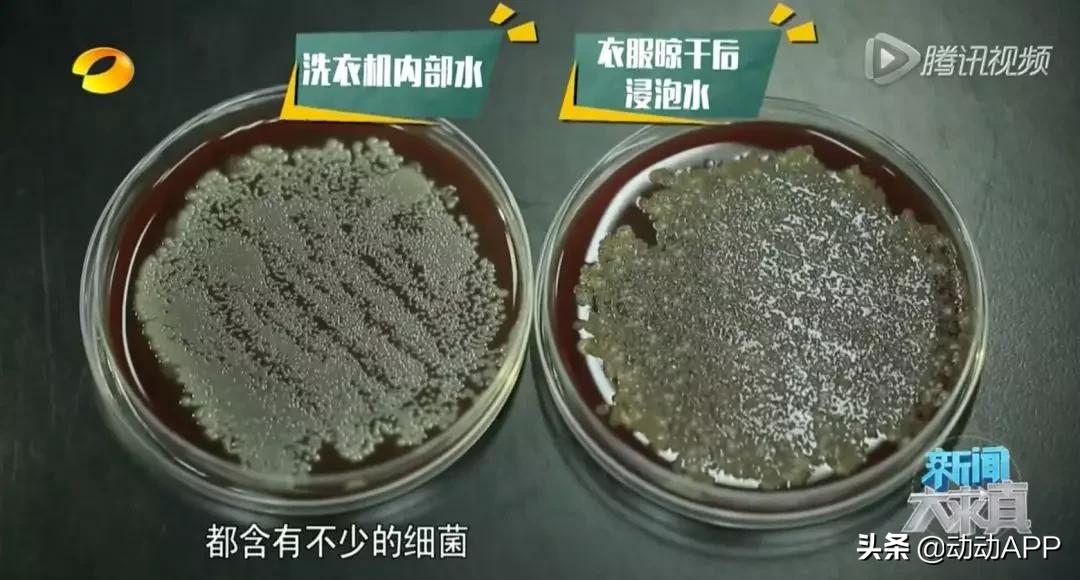
洗衣机里有霉菌,洗衣机放在潮湿的环境有霉菌

【健康科普】
小动君想问大家一个问题
你上一次清洗洗衣机是什么时候?
如果答案是:早已超过3个月
那么小动君不得不提醒你
洗衣机可能正升级为你家最~~脏的地方!
▽▽▽



图片来源 @《新闻大求真》
不要惊讶不用怀疑,如果你长期未清洗洗衣机,那么以上情况,就会出现在你家的洗衣机里!

再来看看这组数据:
上海市疾控中心曾抽样检查了128台使用半年以上的洗衣机,结果显示:
▵ 细菌总数检出率为81.3%
▵ 霉菌检出率为60.2%
▵ 总大肠菌群检出率高达100%
▵ 有54.7%的洗衣机同时含有以上三种菌类

这么多细菌“穿”在我们身上,到底会怎样呢?
▵ 霉菌会导致生殖系统出现炎症。
▵ 如果将内衣*裤内**一起洗,还可能会染上霉菌性疾病,如霉菌性阴道炎、*头龟**炎、皮肤过敏性疾病。
▵ 当人体免疫力低下时(尤其是儿童),还会染上霉菌性肺炎、呼吸系统疾病。
大家可能会问,我每次都用洗衣粉洗衣服呀,也经常擦洗洗衣机外层呀,洗衣机怎么会有那么多细菌?!
-是不是家中的自来水含有细菌?
-当然不是
一起来看看这组「细菌实验」~~湖南省人民医院检验科的医生分别对家中自来水、洗衣机中漂洗衣服的水、洗过的衣服浸泡后的水进行了「细菌检测」。
图片来源:《新闻大求真》
结果发现:
▵ 家里的自来水中是没有细菌的。
▵ 而洗衣机中的水和洗过的衣服浸泡后的水中,都含有不少细菌(大肠杆菌)。
✪ 这说明细菌并不来自家中的自来水,而是来自洗衣机内!!!
-那洗衣机内的细菌从哪里来?
-从看不见的桶内污垢来
其实,无论是波轮洗衣机,还是滚筒洗衣机,它们的工作原理是相通的:
“通过旋转,让衣服和洗衣机的桶壁摩擦摩擦,带走污渍。”

同时,无论是波轮式还是滚筒式洗衣机,都是分两层的,我们平时能看到的内层一般是不锈钢或塑料材质,在内层的背面还有一层(外层)。

图片来源 @《新闻大求真》
洗衣服的时候,水会在内外两层之间流动,所以有很大一部分的空隙,我们是看不到的。
✪ 这两层间,藏有大量的污垢,使用时间越长,污垢越多!

我们该如何清洁洗衣机?
01 洗衣机清洗的间隔不要超过3个月
洗衣机应每隔 1-3 个月清洁一次,可选用洗衣机专用清洁剂+除垢剂(注意不是洗衣粉哦),在家自己进行清洁。
现在很多的滚筒洗衣机还带有清洁功能,并且可以调制成高温模式,选择90度以上的高温是可以消灭绝大多数细菌的!
02 每隔1年大清洁一次
家里的洗衣机应每隔一年左右进行一次大清理。请专业清洗家电的人员上门拆件清理,这些都是我们平时清理不到的污垢。
03 洗完衣服后开盖4小时
滚筒洗衣机的胶皮圈很容易藏污纳垢,这样潮湿的环境会变成细菌生长的摇篮。平时可用废旧牙刷定期清理橡皮圈内的污垢。

洗完衣服后不要立即关上盖子,要打开让内部通风晾干,开盖4小时再关闭。
04 洗完衣服后清洗「过滤器」

图片来源:百度经验
洗衣机的过滤器,主要用来过滤衣服的纤维。长期不清理,里头可是很脏的。快拆开你家的过滤器看看~~

来源:腾讯视频《猫柠》
滚筒洗衣机也有过滤器哦,一般在洗衣机的下方的小方盒中,用起子打开方盒取出过滤器进行清理,如图:



图片来源:百度经验
你们的洗衣机都用对了吗?
分享给家人朋友看,让生活更健康!

